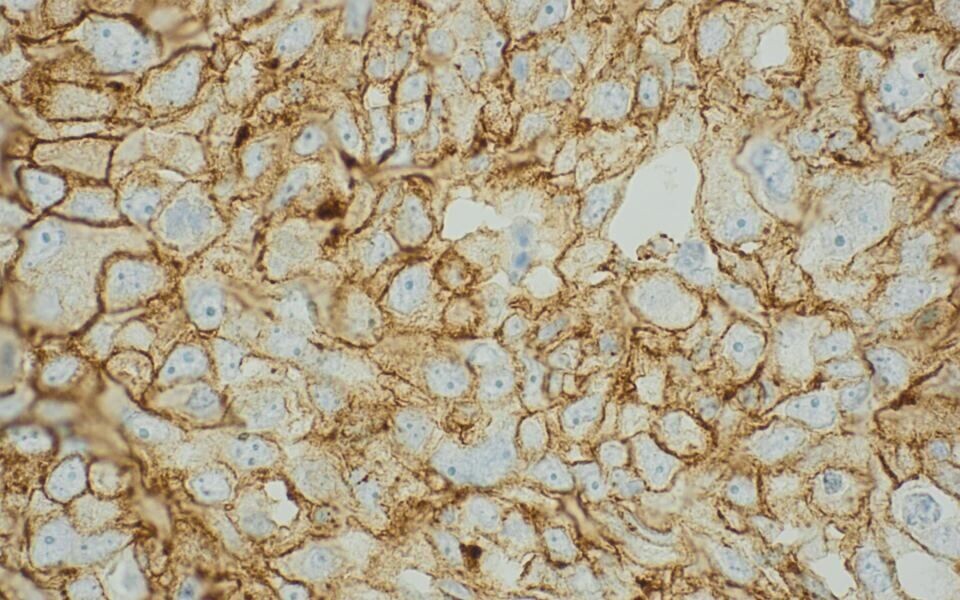
Kreftceller fra pasient som er aktuell for pembrolizumab-behandling. Den brune ringen rundt cellene viser at PD-L1 er til stede. Foto: Universitetssykehuset Nord-Norge

Aktuelt
Ny immunterapi øker presset på patologilaboratoriene
Sju hundre lungekreftsyke i året kan få et lengre liv. Nå skal patologiavdelinger som allerede er hardt presset, finne de som kan ha effekt av den nye behandlingen.
Mandag 26. september fikk mange kreftpasienter en etterlengtet nyhet. Beslutningsforum for nye metoder ga tommelen opp for bruk av det mye omtalte immunterapeutiske legemidlet pembrolizumab til en ny gruppe: Pasienter med såkalt ikke-småcellet lungekreft som har fått tilbakefall etter cellegift. Tidligere har legemidlet vært vurdert som for lite kostnadseffektivt for dette formålet.
Uttrykk av proteinet PD-L1 i kreftceller er indikasjon for behandling med pembrolizumab. Dette påvises ved hjelp av en immunhistokjemisk analyse. Statens legemiddelverk anslår at cirka 1000 pasienter skal testes per år, og at cirka 700 vil være PD-L1 positive.
Må strekke seg lengre
Stavanger universitetssykehus innførte PD-L1-testen i rutinen samme uke som RHF-direktørene i Beslutningsforum tok avgjørelsen om pembrolizumab. I løpet av den første driftsmåneden er det analysert mellom 30 og 40 prøver.
PD-L1 er en ressurskrevende analyse. Pris per test ligger rundt 1000 kroner. Seksjonsleder Ivar Skaland forteller at immunhistokjemilaben kjører analysen én – to ganger i uka. Han anslår at én kjøring utgjør cirka et halvt bioingeniørdagsverk, uavhengig av antallet prøver.
- Vi må bare brette opp ermene og få dette gjort. Pasientene skal ikke vente lenge på svar, sier Skaland.
Han opplever at de ansatte stadig må strekke seg litt lengre.
Dette er bare starten
Ved patologiavdelingen på Universitetssykehuset Nord-Norge (UNN) regner man med 80 – 100 PD-L1-analyser i året.
- Men PD-L1 er bare starten. I tiden fremover kommer nok flere immunterapeutiske medikamenter. Vi må utvide vårt analyserepertoar tilsvarende, for å finne de som kan ha effekt av behandlingen, sier avdelingsleder Kate Myräng.
Hun ønsker tiltak som kan bedre kapasiteten for immunhistokjemi. Innføring av stadig nye immunanalyser er utfordrende, både når det gjelder utstyr og personell. Situasjonen blir ikke enklere av at det, ifølge Myräng, er få kvalifiserte søkere ved utlysning av bioingeniørstillinger.
Kan bli dyrt
Det var i midten av september det ble kjent at legemiddelverket vurderte pembrolizumab som kostnadseffektivt. Et «ja» fra Beslutningsforum lå dermed i lufta. Interessen for PD-L1 steg blant onkologer, og avisa Dagens Medisin skrev at flere patologiavdelinger ikke var klare til å gjøre testen.
- Vi pleier å være en lite synlig del av det medisinske landskapet, men da ble vi veldig populære, bemerker Elin Richardsen.
Hun er patolog ved Universitetssykehuset Nord-Norge og leder av patologforeningens faggruppe for lungepatologi. I samarbeid med Norsk lungekreftgruppe har hun i høst lagd retningslinjer for PD-L1-testing.
Retningslinjene anbefaler primært bruk av kit med et bestemt antistoff fra Dako. Men de kan kun brukes på Dakos maskiner. For laboratoriene som ikke bruker Dako-instrumenter, er en test fra Ventana et alternativ.
- Men dette antistoffet har ikke FDA-godkjenning, slik Dako har, sier Richardsen.
UNN er blant de som bruker Ventana. Richardsen opplyser at det pågår studier av hvilket antistoff som er best. Det vil bli dyrt hvis flere patologiavdelinger må kjøpe nytt instrument for å kunne bruke den anbefalte testen.
Hun er enig med bioingeniørene i at ressurssituasjonen er utfordrende.
- Patologiavdelingene trenger flere bioingeniører og flere patologer, sier hun.
Richardsen tror at patologi fortsatt er synonymt med obduksjon for mange. Når folk vet lite om patologilaboratorienes rolle i kreftdiagnostikken, er det vanskeligere å få gjennomslag i prioriteringskampen.